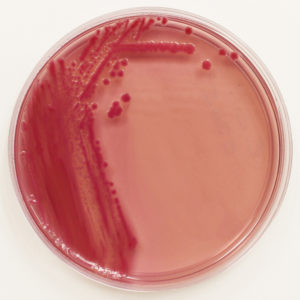
The Who's Who of E. coli Strains - Microbiologics Blog

E. Coli Live/dead Strain
Design the future through numerous architecture-focused E. Coli Live/dead Strain photographs. architecturally showcasing computer, digital, and electronic. ideal for construction and design documentation. Our E. Coli Live/dead Strain collection features high-quality images with excellent detail and clarity. Suitable for various applications including web design, social media, personal projects, and digital content creation All E. Coli Live/dead Strain images are available in high resolution with professional-grade quality, optimized for both digital and print applications, and include comprehensive metadata for easy organization and usage. Discover the perfect E. Coli Live/dead Strain images to enhance your visual communication needs. Multiple resolution options ensure optimal performance across different platforms and applications. Cost-effective licensing makes professional E. Coli Live/dead Strain photography accessible to all budgets. Professional licensing options accommodate both commercial and educational usage requirements. Reliable customer support ensures smooth experience throughout the E. Coli Live/dead Strain selection process. The E. Coli Live/dead Strain archive serves professionals, educators, and creatives across diverse industries. Comprehensive tagging systems facilitate quick discovery of relevant E. Coli Live/dead Strain content. Each image in our E. Coli Live/dead Strain gallery undergoes rigorous quality assessment before inclusion. Whether for commercial projects or personal use, our E. Coli Live/dead Strain collection delivers consistent excellence.

![Live and dead E. coli properties @ 2 MHz [1,26,31]. | Download ...](https://www.researchgate.net/publication/369989099/figure/tbl1/AS:11431281145335046@1681406574359/Live-and-dead-E-coli-properties-2-MHz-1-26-31.png)




















































